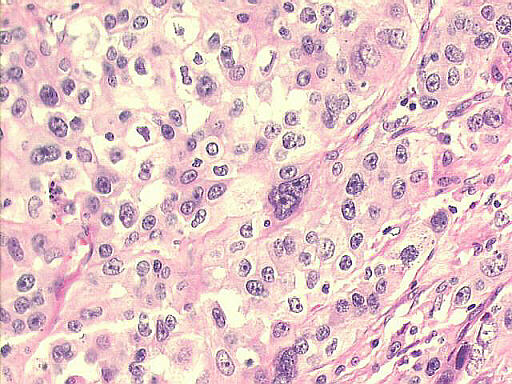
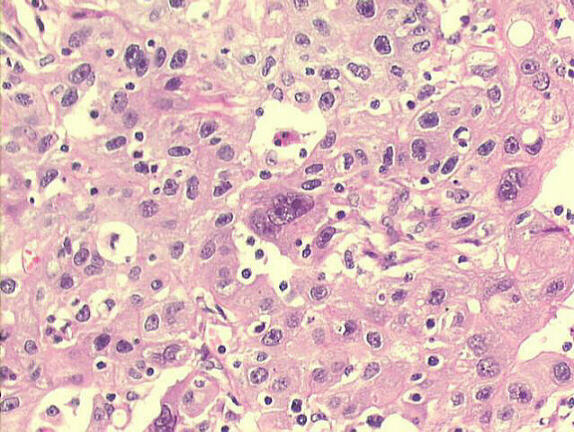

Dr Prolla's INTERESTING CASE OF THE MONTH - June 2000
|
Immunohistochemistry:
giant cells positive for keratin and negative for vimentin:
Presence of many
giant cells in an invasive ductal cell carcinoma; the epithelial nature
of these giant cells was confirmed by immunohistochemistry: they were positive
for keratin and negative for vimentin. Osteoclast-like giant cells are occasionally seen in breast carcinomas, most of them moderately or poorly differentiated invasive ductal carcinomas, with foci of metaplastic areas - with squamous or osseous features. These osteoclast-like giant cells are found in the stroma, have an immunohistochemistry profile of histiocytic or osteoclasts of bone, and do not have the epithelial immune
reactivity of the truly neoplastic giant cells, as seen in our case.
Hospital de Clinicas de Porto Alegre, Pathology
& Cytopathology Laboratories
|

| References | List of cases |